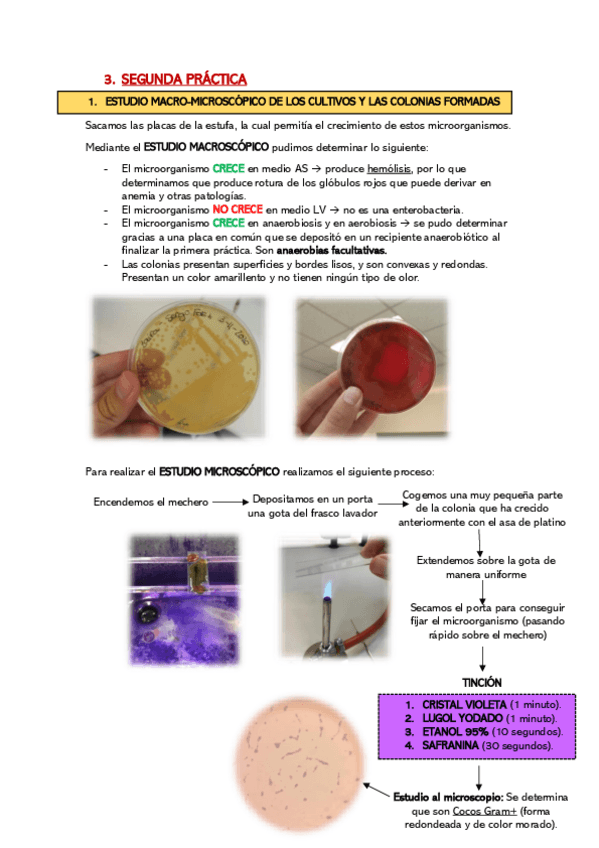

@SergioFdez11
Estudios: Grado en Veterinaria (UEX)
4 Publicaciones
300 Interacciones
1 Seguidores
1 Siguiendo
Lista de publicaciones de SergioFdez11
He publicado nuevos apuntes de 4º PATOLOGÍA MÉDICA Y DE LA NUTRICIÓN II: TRATAMIENTOS-MEDICA-II.pdf
He publicado nuevos apuntes de 2º Microbiología: CUADERNO-MICROBIOLOGIA.pdf
He publicado nuevos apuntes de 2º Anatomía Patológica General: APG-SERGIO-COMPLETO.pdf
He publicado nuevos apuntes de 2º Parasitología: PARCIAL-PARASITO-Fdez-Bote-Sergio.pdf